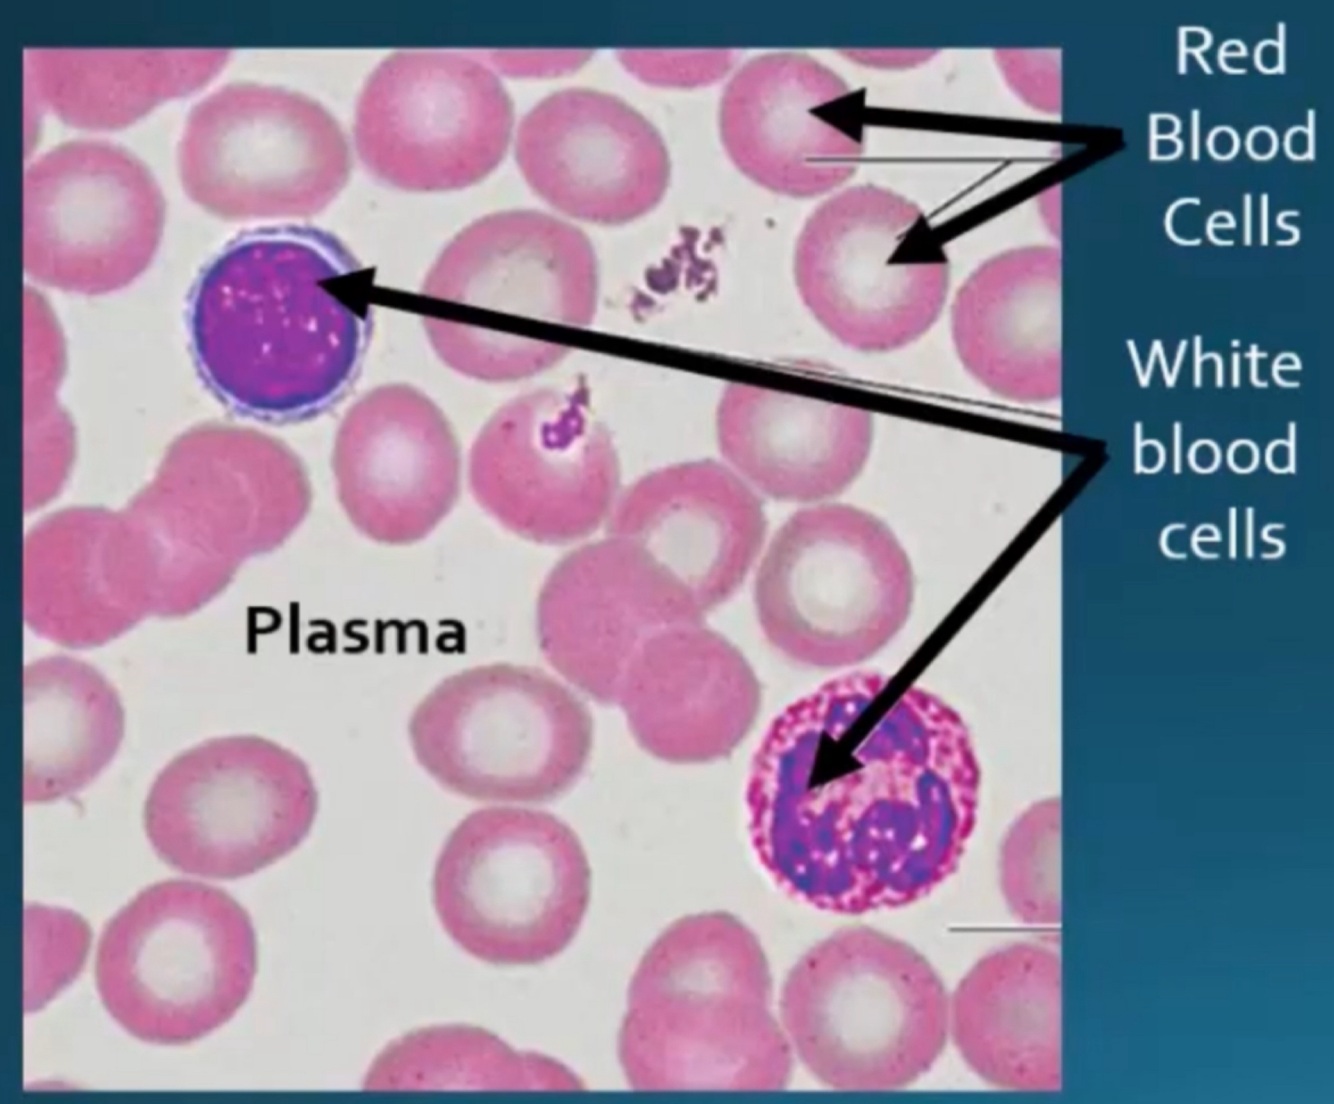

Functions Connective tissue
- Binding and supporting
- Protecting
- Insulating
- Storing reserve fuel
- Transporting substances
Ground substance
clear, colourless, viscous fluid that fills the space between the cells and fibres
3 Types of fibres
(1) Collagen
(2) Elastic
(3) Reticular
Collagen Fibre
fibrous protein that is extremely tough and provides high tensile strength
Elastic Fibre
Long thin fibres that stretches and recoil
Reticular Fibre
Short, fine collagenous fibres that branch to form networks
Cyte vs blast
cyte
- mature
- maintain the health of the matrix
- can revert to their active, immature state to repair and regenerate the matrix.
blast
- immature cell
- Actively proliferating and secreting the ground substance and the fibres characteristic to their particular matrix
Connective tissue proper:
Loose Areolar
- Supporting and binding other tissues
- Defending against infection
- Holding body fluids
- Storing nutrients
Under epithelia, surrounds capillaries.

Connective tissue proper:
Loose Adipose
- Store Energy (Lipids)
- Cushions and insulates the body
Under skin, around kidneys and eyes. Abdomen and breasts.

Connective tissue proper:
Loose Reticular
- Internal framework that can support immune cells
- Lymphoid organs.

Connective tissue proper:
Dense Regular
tensile strength of collagen, this tissue forms tendons, cords that attach muscles to bone

Connective tissue proper:
Dense irregular
Found in areas where tension is exerted from many different directions
Part of the skin dermis area and in the fibrous joint capsules of the limb

Connective tissue proper:
Dense Elastic
Allow the tissue to recoil after stretching
Walls of bronchial tubes.

Hyaline cartilage
Provides strong support while providing pads for shock absorption
respiratory system

Elastic cartilage
Maintain the shape of the structure while allowing flexibility
Skeleton of the external ear and in the epiglottis

Fibrocartilage
Compressible and resists tension.
Found in the intervertebral discs of the bony vertebrae and knee meniscus.

Bone: functions
Supports and protects body structures
Stores calcium and other materials and fat
bone marrow = site for synthesising blood cells

Bone (appearance)
Hard, light weight. Strong
Osteons - canals with blood vessels and nerves.

blood
Delivers necessary substances such as nutrients and oxygen to the cells
transports metabolic waste products away from those same cells.
What fibre type in connective tissue cross links together to provide high tensile strength to resist stretching and give ligaments and tendons their resilience and strength?
collagen
What is A?

Elastic fibres
What is B?

Reticular fibres
What is C?

Collagen fibers
What is D?

Fibroblast







